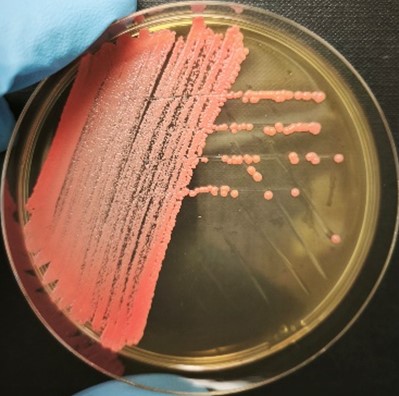
<em>Rhodotorula sphaerocarpa</em> IST816
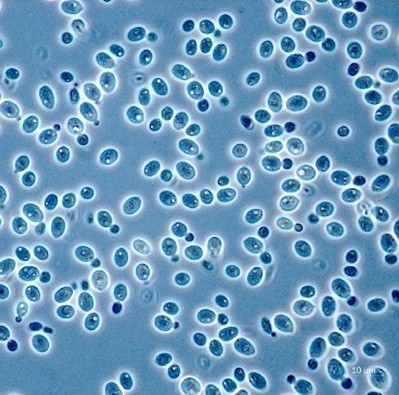
<em>Rhodotorula sphaerocarpa</em> IST816 - Image 2

Your cart is currently empty!
Rhodotorula sphaerocarpa IST816
| Kingdom: | Fungi |
|---|---|
| Phylum: | Basidiomycota |
| Class: | Microbotryomycetes |
| Order: | Sporidiobolales |
| Family: | Sporidiobolaceae |
| Genus: | Rhodotorula |
| Species: | Rhodotorula sphaerocarpa |
| Level of Identification: | Species – Molecular Identification |
| Identificator(s): | Isabel Sá-Correia (iBB, IST, ULisboa), Madalena Matos (iBB, IST, ULisboa), Mónica Fernandes (iBB, IST, ULisboa) |